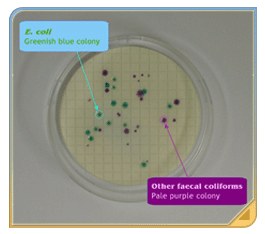

| Monitoring of Beach Water Quality |  |



| Current water sampling and site measurement (left), contrasted with fieldwork in the 1990s (middle) and the 1980s (right) |
Water sampling is carried out frequently and regularly. At gazetted beaches,
the EPD takes samples at least three times a month during the swimming
season, and at least once a month outside the season. A few gazetted
beaches stay open throughout the year, and at these the EPD continues
to take samples at least three times a month for the whole year.
Sampling is regular but it does not conform to any rigid monitoring timetable. Instead, EPD staff select a random day during the week to take samples, including days on weekends and public holidays. The reason for this is that a rigid sampling timetable can miss important trends or events that may occur regularly on a certain days, e.g. only on weekends. Random sampling picks up on these kinds of incidents, and thus provides a more accurate picture of beach water quality over a season.

|
To obtain a water sample, the EPD's inspectors wade a short distance out from the shoreline, generally standing in the sea at thigh to waist level. Once taken, the samples are kept at around 4 degrees Celsius until testing. Besides taking sea water samples, inspectors also sample water from streams or drains that flow near the beach, as a way of checking and identifying possible sources of pollution.
Besides the actual sampling, the EPD's inspectors enter other useful information into the mobile data storage devices (PDA units) they carry. This may include information such as water temperature, the level of dissolved oxygen in the water, local weather conditions, and any other information that could be relevant to beach water quality and the environment. Once entered in their PDA, all this information can be easily uploaded directly onto EPD's office server.

|
In 1987, the EPD established its own Environmental Microbiology Laboratory for analysing all its beach water samples. From this date it also replaced the old Multiple Tube Method with an improved membrane filtration method, which gives much more accurate results. This system has been in use ever since, but the medium used to cultivate E. coli bacteria was further improved in 1997 when a chromogenic medium (CLECC) was introduced, and reporting time was shortened from three to just one and a half days.
The beach water samples are tested for E. coli bacteria at the EPD laboratory within six hours of collection. The membrane filtration method involves passing the water through a membrane filter, which retains bacteria in the water. The membrane is then placed on a special culture medium and incubated for 18 to 24 hours at 44.5 degrees Celsius, in aerobic conditions. During this time any trapped E. coli bacteria develop into distinctive greenish-blue spots (colonies) on the surface of the membrane. Each greenish-blue colony is recorded as an occurrence of E. coli in the water sample. The samples are also measured for pH, salinity and turbidity.
The sampling and testing procedures have been refined and streamlined over the years, and today the EPD system is recognised as scientifically sound and reliable.